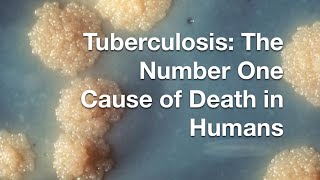

The Deadliest Infectious Disease of All Time | Crash Course Lecture video
Online izle ve mp4 mp3 formatlarinda yukle

Videonun muddeti: 49:57
The Deadliest Infectious Disease of All Time | Crash Course Lecture videosu mp4 ve mp3 yuklemek ucun hazirdir
Diqqet! Siz Mp4 yukle ve ya Mp3 yukle duymesine basdiqdan sonra eger sistem sizi reklam sehifesine atarsa o zaman derhal geri qayidib emeliyyati tekrar edin ve faylin yuklemek ucun hazir olmasini gozleyin
Videodan Mp4 Yukle
Videodan Mp3 Yukle-1
Videodan Mp3 Yukle-2
Oxshar Axtarishlar
 The Deadliest Infectious Disease of All Time | Crash Course Lecture
The Deadliest Infectious Disease of All Time | Crash Course Lecture 32. Infectious Disease, Viruses, and Bacteria
32. Infectious Disease, Viruses, and Bacteria The diseases that changed humanity forever - Dan Kwartler
The diseases that changed humanity forever - Dan Kwartler What makes tuberculosis (TB) the world's most infectious killer? - Melvin Sanicas
What makes tuberculosis (TB) the world's most infectious killer? - Melvin Sanicas Infectious Disease Review Questions - CRASH! Medical Review Series
Infectious Disease Review Questions - CRASH! Medical Review Series How Tuberculosis Become the Deadliest Disease of All Time-Bio 30 SDS
How Tuberculosis Become the Deadliest Disease of All Time-Bio 30 SDS Why is TB still the deadliest infectious disease? | Wellcome
Why is TB still the deadliest infectious disease? | Wellcome Can you get HIV through...watch now to stay informed with infectious diseases physician Dr.Issa.#HIV
Can you get HIV through...watch now to stay informed with infectious diseases physician Dr.Issa.#HIV Infectious Diseases Overview, Animation
Infectious Diseases Overview, Animation
Video Mp4 Mp3Azwap.Biz
Azwap.Biz 2021-2023


 The Deadliest Infectious Disease of All Time | Crash Course Lecture
The Deadliest Infectious Disease of All Time | Crash Course Lecture 32. Infectious Disease, Viruses, and Bacteria
32. Infectious Disease, Viruses, and Bacteria The diseases that changed humanity forever - Dan Kwartler
The diseases that changed humanity forever - Dan Kwartler What makes tuberculosis (TB) the world's most infectious killer? - Melvin Sanicas
What makes tuberculosis (TB) the world's most infectious killer? - Melvin Sanicas Infectious Disease Review Questions - CRASH! Medical Review Series
Infectious Disease Review Questions - CRASH! Medical Review Series How Tuberculosis Become the Deadliest Disease of All Time-Bio 30 SDS
How Tuberculosis Become the Deadliest Disease of All Time-Bio 30 SDS Why is TB still the deadliest infectious disease? | Wellcome
Why is TB still the deadliest infectious disease? | Wellcome Can you get HIV through...watch now to stay informed with infectious diseases physician Dr.Issa.#HIV
Can you get HIV through...watch now to stay informed with infectious diseases physician Dr.Issa.#HIV Infectious Diseases Overview, Animation
Infectious Diseases Overview, Animation